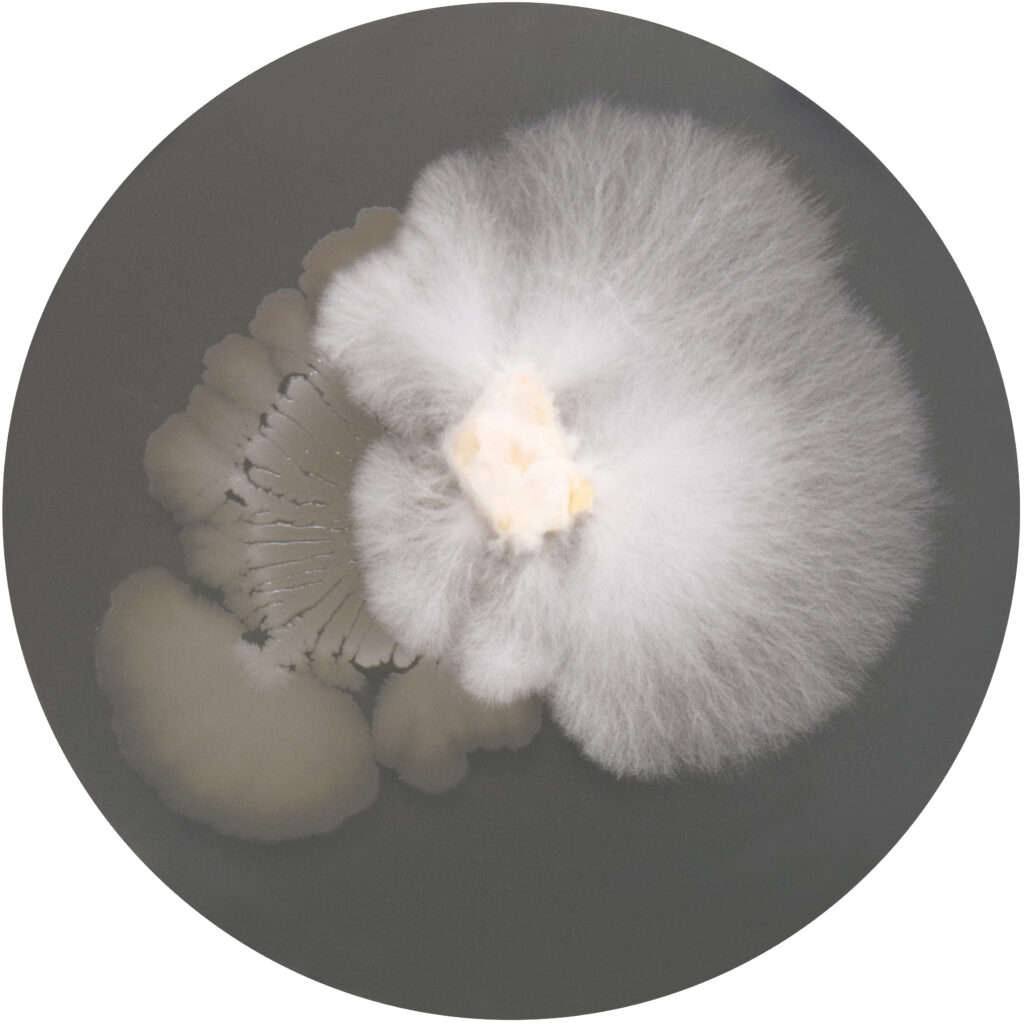
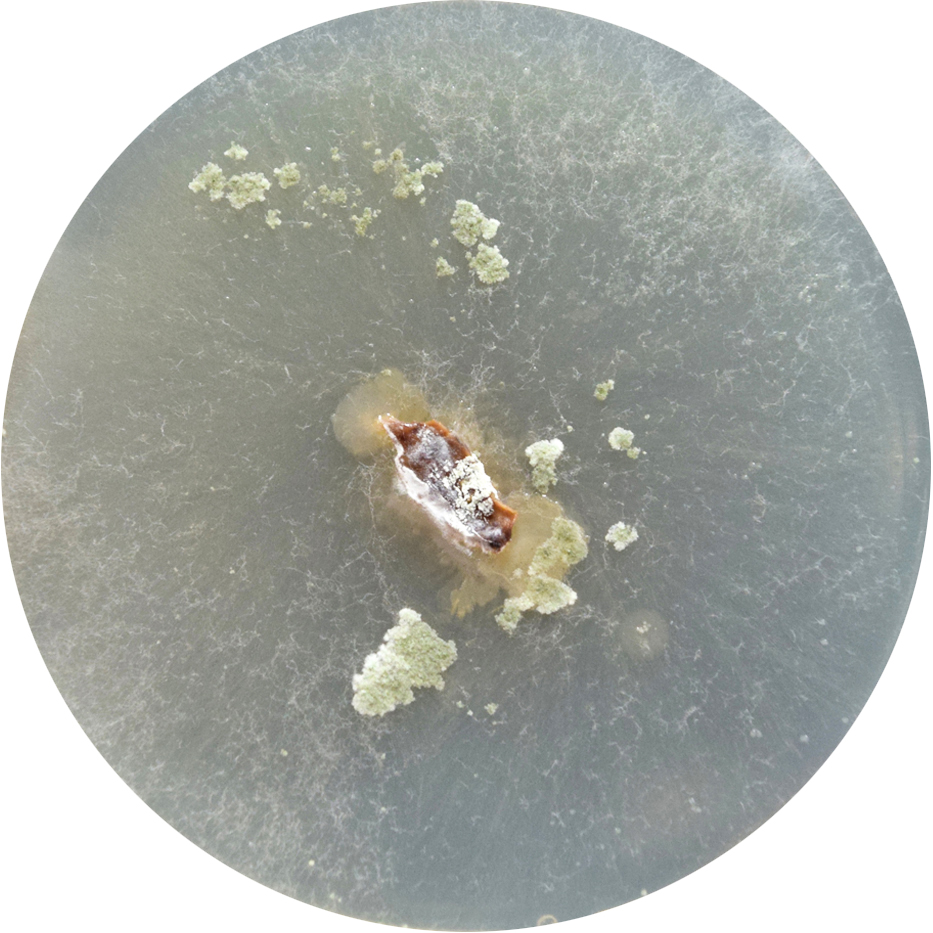
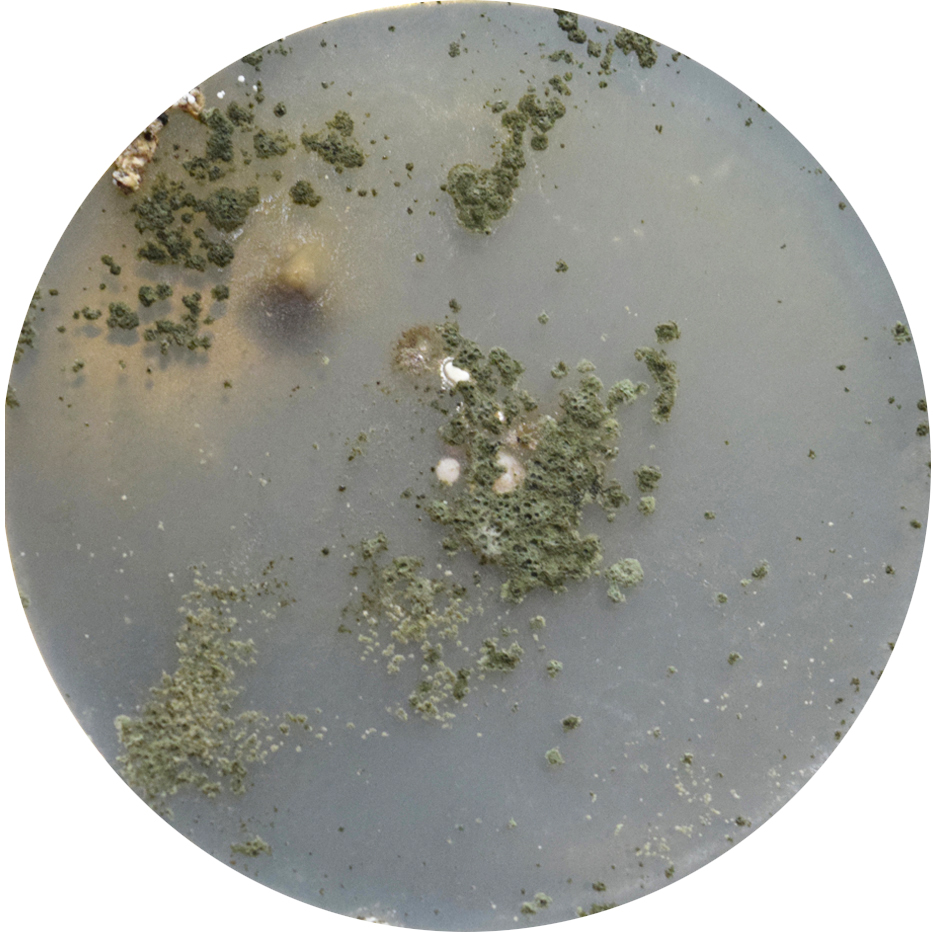
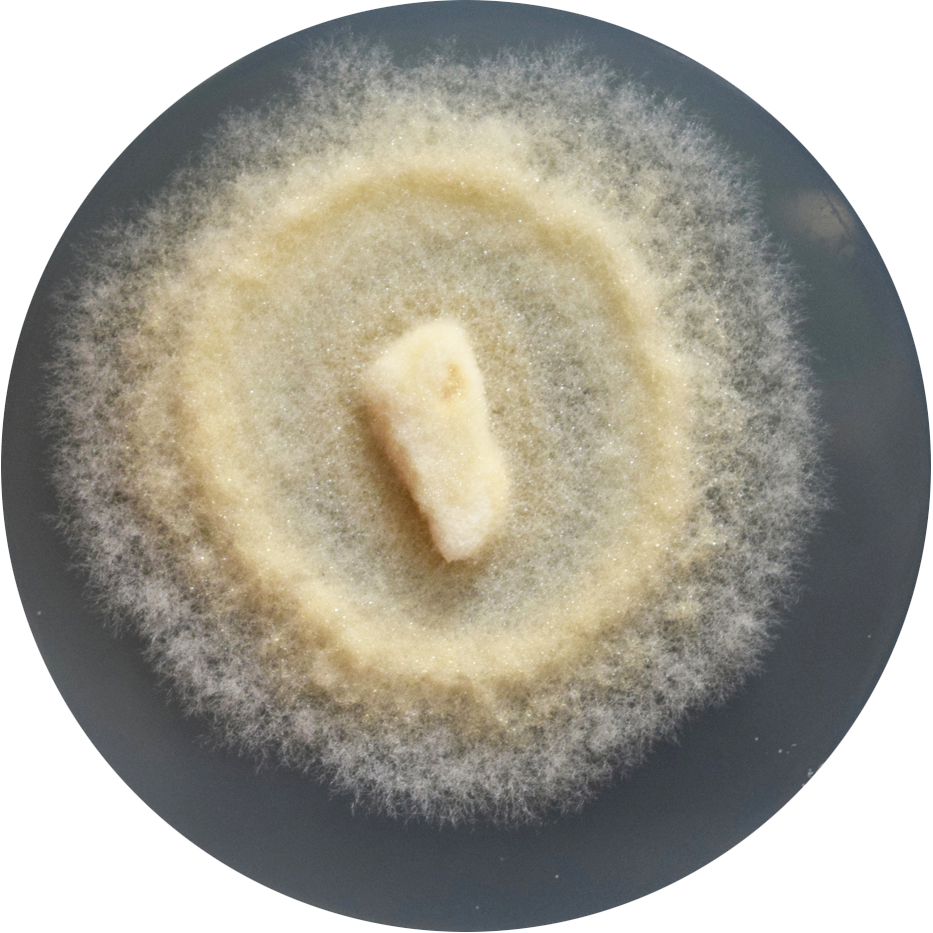
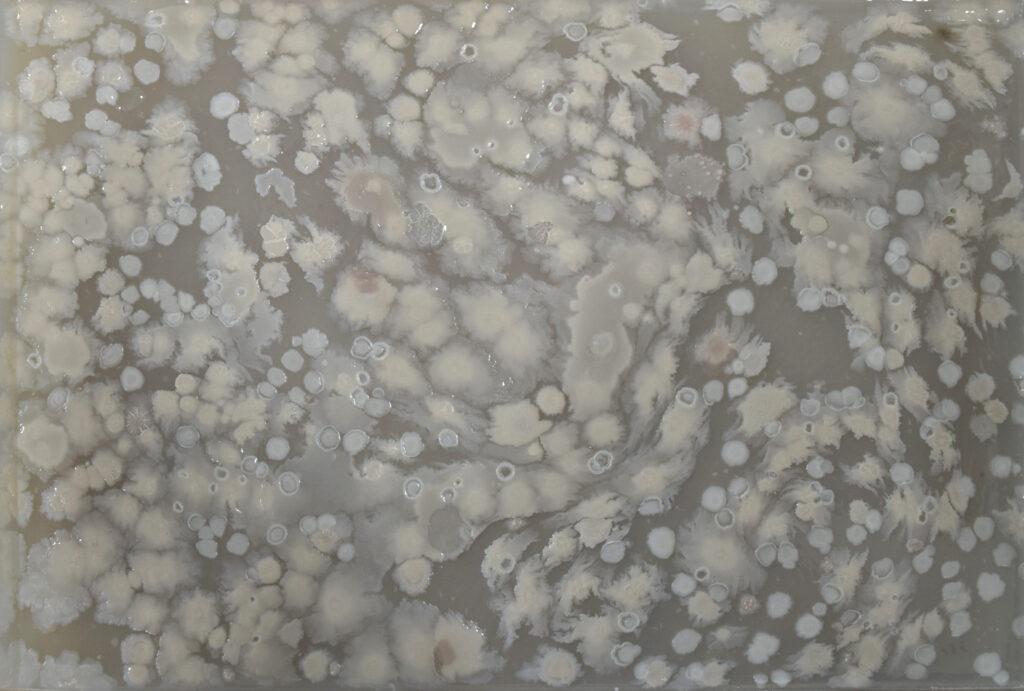

EL REINADO DE LOS HONGOS

Rodrigo Arteaga (1988, Santiago)
2022
Mycelium Book de Rodrigo Arteaga surge como un libro expandido, un objeto que no busca fijar un relato sino abrirlo en múltiples direcciones. Concebido durante una residencia en el Centre for Print Research de la University of the West of England (UWE) en Bristol, la obra transforma la lógica editorial en un terreno experimental: entre microscopios, placas de petri, agar y caminatas por el bosque, cada fragmento se convierte en huella de un proceso más que en obra acabada.
Bajo el lente fungi, este libro se entiende como organismo: una red de impresiones, objetos y poemas que crece, se dispersa y se descompone. No hay linealidad, sino expansión; no hay clausura, sino ramificación. Mycelium Book propone leer y escribir como lo hace el micelio: infiltrándose en el sustrato, erosionando sus formas y recomponiéndolas en un lenguaje vivo que nunca termina de fijarse.

Equipo
Proyecto
En su desarrollo, Mycelium Book incorpora técnicas diversas: grabados que reproducen redes observadas al microscopio, placas fotosensibles expuestas directamente al micelio, letras de madera inoculadas con Pleurotus ostreatus (champiñón ostra) para escribir “poemas fúngicos”. Cada procedimiento es a la vez dispositivo de observación y gesto de colaboración con los hongos, donde la materia se convierte en trazo y el tiempo en inscripción.
El resultado es un libro-caja que se despliega como un archivo vivo: impresiones, fragmentos y objetos que funcionan como invitaciones a seguir un proceso abierto más que como colecciones cerradas. Como el suelo que guarda y transforma, Mycelium Book propone una lectura donde cada página es un umbral, cada huella una señal de lo que se expande y se transforma bajo la superficie.
Fotografías: Simon Regan
Despliegue: Lizzie Field









Ficha técnica
Año: 2023
Materiales: papel japonés, papel Somerset, papel digital Hahnemühle, lupa, caja de petri, madera, caja encuadernada
Medio: intaglio, fotograbado en polímero, impresión inkjet
Dimensiones: 21,5 × 29 × 5 cm
- Caja de coleccionista encuadernada en lino verde salvia, con estampado en plata en tapa y lomo.
- Página de agradecimientos impresa en tinta blanca UV.
- Inserto troquelado en láser con caja de soporte en bajorrelieve que contiene:
- Placa de Petri de vidrio (9 cm de diámetro) con 14 impresiones de micelio cortadas digitalmente sobre papel Somerset Book.
- Lupa de vidrio y metal (15 x 6,5 cm).
- Sobre plegado de papel kraft (7,9 x 10,3 x 0,9 cm) con 22 impresiones inkjet en papel mate (10 x 7,5 cm).
- Serie de impresiones:
- 5 impresiones inkjet recortadas a mano (hoja, corteza, hongos).
- 1 fotopolímero sobre partitura (26,2 x 19,3 cm).
- 1 fotopolímero sobre papel japonés (15,3 x 11 cm).
- 1 impresión inkjet sobre papel japonés (26,6 x 39,7 cm).
- Impresiones inkjet sobre papeles Hahnemühle y Somerset de distintos formatos (de 4,5 x 8 cm a 54 x 39,5 cm).
- 1 impresión de hoja recortada a mano, fotopolímero y aguafuerte sobre papel Somerset (25 x 16,5 cm).
- Varias impresiones en fotopolímero y aguafuerte sobre papel Somerset.
- Impresiones inkjet en papel mate y gloss de diversos formatos.
Edición limitada de 20 ejemplares, firmada y numerada por el artista.
Parte de la colección CFPR Editions.
Impresiones realizadas por Laura Clarke
Encuadernación y caja de lino realizada por Bristol Bound Bookbinders

Durante su residencia en el Centre for Print Research, Rodrigo Arteaga transformó el taller de impresión en un laboratorio vivo, un punto de encuentro entre el bosque y el estudio. Cada día recolectaba muestras de hongos en los alrededores de Bristol: Leigh Woods, Snuff Mills, Stoke’s Park, para luego cultivarlas en placas de Petri, biobandejas y vitrinas de vidrio. La rutina de caminar, observar, oler y registrar se convirtió en un ritual de aprendizaje: dejar que el micelio marcara el ritmo, aceptar la incertidumbre de los procesos vivos y permitir que las ideas se expandieran como esporas al vuelo.
La residencia se convirtió en una constelación de experimentos simultáneos: aguafuertes que imitaban redes miceliales observadas al microscopio, micelios expuestos directamente sobre placas fotosensibles, letras de madera inoculadas con hongo ostra para escribir “poemas fúngicos”. Como el micelio mismo, los proyectos crecieron en múltiples direcciones, generando conexiones con impresores, científicos y otros artistas. En ese ecosistema colaborativo, Mycelium Book tomó forma: no como un libro lineal, sino como un archivo vivo que recoge la energía del laboratorio, el bosque y la práctica artística en un solo gesto.





“La residencia se convirtió en un laboratorio para pensar, observar y dejar que las ideas y los procesos crecieran, como si uno se retirara poco a poco y permitiera que los hongos se manifestaran.”








Indeterminacy
La noción de ‘Indeterminacy‘, desarrollada por John Cage, ha sido un referente crucial para Rodrigo Arteaga, quien además de artista visual es músico. Cage (1912–1992) fue un compositor y pensador estadounidense, pionero de la música experimental, célebre por obras como 4’33’’ y por su interés en el azar, el silencio y la disolución de las fronteras entre arte y vida. Su fascinación por los hongos lo llevó a cofundar en 1962 la New York Mycological Society, uniendo práctica artística y micología en una misma curiosidad vital. En ese mismo espíritu, Arteaga concibe obras como Mycelium Book no como objetos fijos, sino como procesos abiertos a la colaboración con organismos vivos. Así como Cage liberaba la composición musical de la intención autoral para escuchar lo imprevisible, Arteaga deja que el micelio trace sus propios dibujos y que la descomposición y el tiempo se conviertan en parte constitutiva de la obra.



HIJUELO N 1
Durante la residencia en el Centre for Print Research, Rodrigo Arteaga trabajó junto al compositor Félix Pino-Kovalenko en una experimentación que extendió su diálogo previo entre arte visual y sonido. Juntos exploraron cómo traducir el comportamiento del micelio en una estructura musical, imaginando una partitura circular inspirada en las placas de Petri: cada intérprete ejecuta un cuarto del círculo, siguiendo la lógica ramificada y simultánea del crecimiento fúngico. Este ejercicio, parte de una colaboración más extensa entre ambos, plantea una escucha micelial: una composición que no progresa en línea recta, sino que se expande, se superpone y se transforma, como una red viva.
Cada ejecutante de los grupos 1, 2, 3 y 4 interpreta la partitura desde el centro hacia los extremos, eligiendo qué línea ritmo-melódica cantar o interpretar. Los círculos marcan el tiempo por segundos. El registro medio es el trayecto entre el centro y las esquinas asignadas con el número de cada grupo. Las variaciones de tono se interpretan de la siguiente manera:
↓↑↑↓
↑↓↓↓

Otro componente singular de este proceso fue el registro tridimensional de un liquen mediante fotogrametría, realizado durante la residencia en el CFPR. Esta experimentación permitió trasladar al espacio digital un organismo que ya es simbiosis —hongo y alga—, expandiendo el campo de Mycelium Book hacia una dimensión escultórica y especulativa, donde lo micelial se piensa también como modelo tecnológico y simbiótico.








“Mi amiga Giuliana Furci, que es una gran inspiración, siempre dice: ‘tenemos que dejar que las cosas se pudran’. Debemos realmente elevar el proceso de descomposición y recomposición… hasta volverlo casi sagrado.”

Sobre el brochure
El brochure de Mycelium Book reúne los textos que contextualizan y acompañan la obra de Rodrigo Arteaga. Incluye el prólogo de Giuliana Furci, fundadora de la Fungi Foundation, además de reflexiones curatoriales y descripciones del proceso creativo desarrollado en Bristol. El documento funciona como un marco editorial que presenta la obra no solo como un libro de artista, sino como un archivo vivo de experimentación con hongos, técnicas gráficas y escritura fúngica.







“All Fall / Cada Caída” es una colaboración con Luna Montenegro y Adrian Fisher, autores del texto que Rodrigo Arteaga utilizó como base para su poema fúngico.
Desde su concepción en el Centre for Print Research (UWE, Bristol), Mycelium Book ha encontrado múltiples plataformas de exhibición en Europa y Latinoamérica. Ha sido presentado en el Literarisches Museum Max-Eyth-Haus (Kirchheim, 2023) dentro de la muestra Mushroom Variations; en el Deutsches Romantik Museum (Frankfurt, 2023) en diálogo con archivos botánicos; y en el Museum Sinclair Haus – Stiftung Kunst und Natur (Bad Homburg, 2024), donde se inscribió en un marco de micologías artísticas contemporáneas. Asimismo, el proyecto ha circulado en espacios de investigación como el Centre for Print Research de la UWE y en instituciones como el ACC Galerie Weimar, consolidándose como un ensayo visual y editorial que conecta prácticas gráficas, micología y pensamiento ecológico.













En el marco de El Reinado de los Hongos, Mycelium Book se presenta como un archivo vivo que desborda la noción de libro y de escritura. No es un contenedor de páginas, sino un organismo editorial donde grabado, impresión, objeto y simbiosis se entrelazan para pensar desde lo fungi. La obra de Rodrigo Arteaga nos recuerda que los hongos no solo transforman la materia, también transforman el lenguaje: lo abren, lo dispersan, lo hacen crecer en direcciones inesperadas.
En un tiempo marcado por crisis ecológicas y epistemológicas, este libro-micelio asume la ambigüedad propia de los hongos: su potencia para nutrir y parasitar, para sostener y descomponer, para desbordar las fronteras entre cultura y naturaleza. Frente a la ilusión de permanencia, Mycelium Book insiste en la transitoriedad; frente a la linealidad de los relatos, propone ramificación. La inteligencia que aquí se despliega no es un atributo individual, sino una práctica de interdependencia: una escritura compartida entre artista y organismo, entre laboratorio y bosque, que nos recuerda que lo que fermenta en la penumbra puede acabar reconfigurando todo lo que vemos en la superficie.

